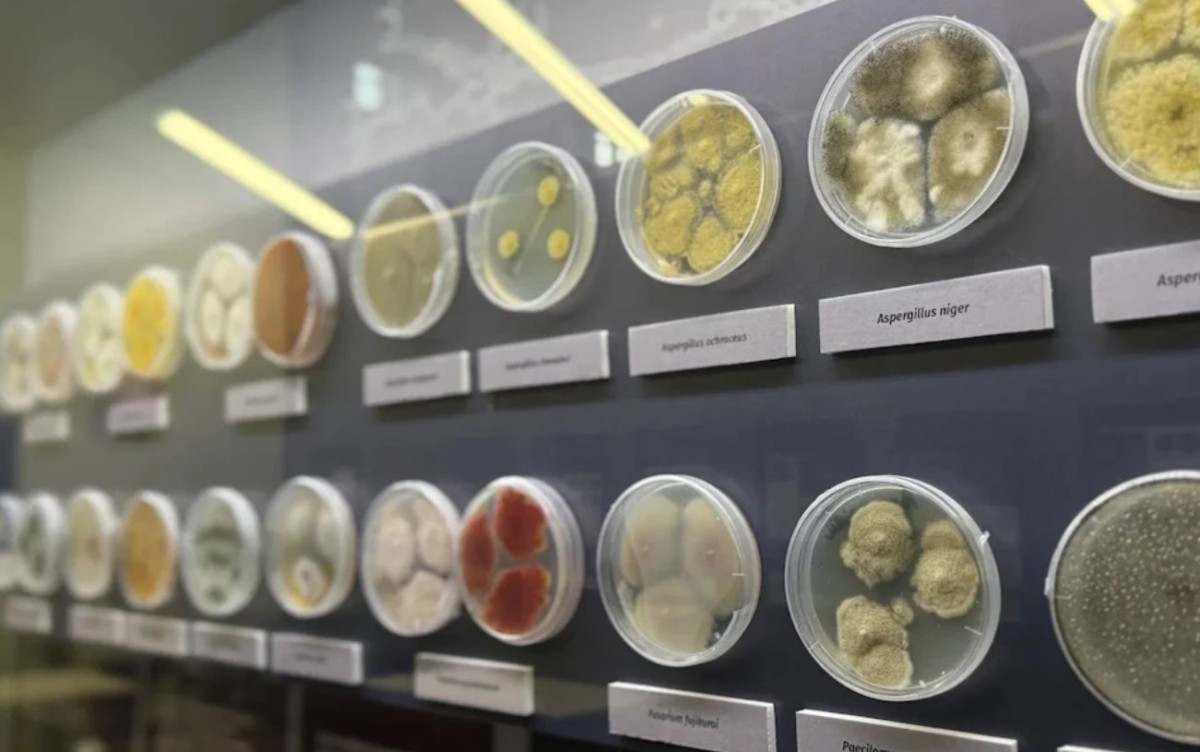

Выставка в московском биокластере
Чтобы ответить в этой теме, войдите на сайт.
- В этой теме 0 ответов, 1 участник, последнее обновление 5 месяцев, 1 неделя назад сделано
Grigory Peshkin.
-
АвторСообщения
-
20 ноября 2025 в 14:12 #256714
Grigory PeshkinУчастникМосквичей пригласили на необычную выставку о плесени в столичный биокластер
В Биокластере на ВДНХ открылась необычная выставка «Тайная жизнь плесени: микромицеты жилых помещений», где представлены живые культуры микроскопических грибов. Экспозиция будет работать до 30 ноября в павильоне №31 «Геология».
Как рассказала куратор выставки Ольга Зубарева, ученый секретарь Биологического музея им. К.А. Тимирязева, проект позволяет заглянуть в невидимый невооруженным глазом мир микроорганизмов, которые окружают человека в повседневной жизни.
«Не только изучать, но и показывать микроорганизмы очень сложно, лишь немногие музеи мира это делают. Самый известный музей, полностью посвященный микроорганизмам и доступный для широкой публики — Микропия, он находится в Амстердаме. Наша небольшая выставка в Биокластере — это редкая возможность для всех увидеть живые культуры микроорганизмов в Москве», — отметила Зубарева.
Что увидят посетители?
Вместо традиционных экспонатов гости выставки увидят научные образцы в герметично закрытых чашках Петри. Особенность экспозиции в том, что представленные культуры продолжают расти, и их внешний вид меняется ежедневно.Выставка раскрывает удивительные свойства микромицетов. Например, некоторые виды грибов участвовали в космических экспедициях, проводя более месяца на внешней стороне космического аппарата. Другие виды сыграли ключевую роль в истории медицины — именно плесень рода Penicillium позволила Александру Флемингу открыть пенициллин.
Отдельное внимание уделено применению микроскопических грибов в пищевой промышленности. Посетители узнают, как Penicillium используется при производстве голубых сыров, а Botrytis cinerea помогает создавать элитные вина. Разные виды плесени активно участвуют в создании различных продуктов питания.
Экспозиция не только демонстрирует многообразие микромицетов, но и объясняет методы работы с ними. Гости узнают, как собирают пробы микроорганизмов из воздуха, что такое «чистые культуры» и как сохраняют культуры в течение многих лет. Этими и другими профессиональными секретами специалисты-микологи делятся с посетителями выставки.
-
АвторСообщения
- Для ответа в этой теме необходимо авторизоваться.